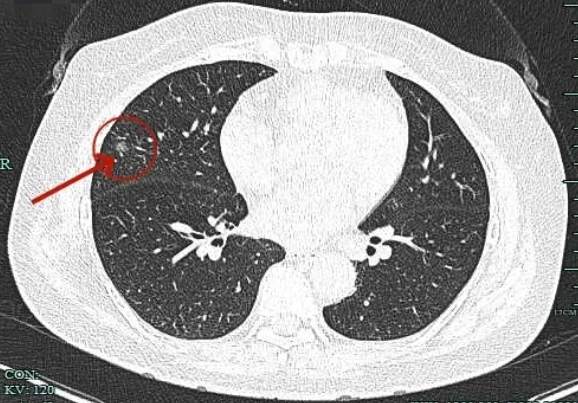
img
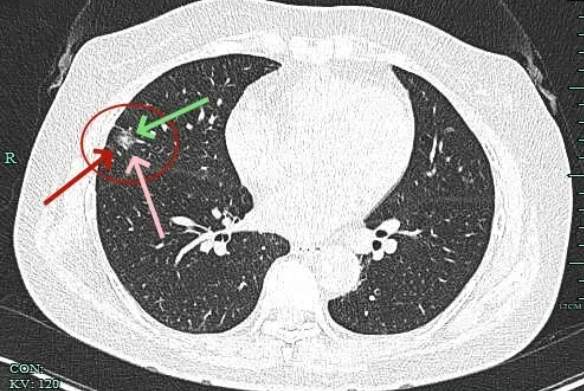
img

肺结节,直接可以切了!
李梦杰huxi 达人已点赞查出肺部结节,特别是到了医生自己亲人或亲戚身,总下不了决心,轻易说是恶性,怕决定手术后结果不是;说考虑不是恶性,又怕真恶性延误治疗。所以即使影像比较典型,也容易下不了决心些,而再叫外人来看,则旁观者清。其实这和外科医生碰到术后出血要不要二次手术探查的心理是类似的。再开一刀,怕本来不开也能保守治疗成功;不开以怕延误病情与治疗,而在主刀医生以外的医生来看,则容易决定得多,相对也更加积极主张手术些
病史信息:主诉:【检查发现肺部结节1月余]
现病史:【1月余前患者无明显诱因出现咳嗽,咳白色粘痰,无发热畏寒,无胸闷气急,无咯血胸痛等不适,患者遂至当地**市中医院就诊,复查胸部CT提示右肺中叶结节,肺癌不除外,建议定期复查,患者决定行手术治疗,遂拟“右肺部阴影”收入院。病来患者精神可,胃纳、睡眠一般,二便无殊,近期体重无明显增减。高血压病史10余年,口服药物不详,自诉血压控制可。
检查发现肺结节,有咳嗽症状,CT示右中叶结节,肺癌不除外。
影像展示与分析:
病灶出现,磨玻璃密度,轮廓较清,此层示见显著实性成分。
边缘不平有毛刺,实性成分开始出现,外周仍是磨玻璃密度的。血管与之关系密切。

典型毛刺征,磨玻璃部分瘤肺边界清,表面不平,灶内密度不均。

实性成分占比高,表面不平,有细毛刺征,整体感觉有一定收缩力。

病灶大部分实性,边缘细毛刺与少许磨玻璃成分。

感觉整体病灶有膨胀性,边缘有毛刺征,灶内密度不是太致密。

叶间胸膜受牵拉凹陷,有微小血管进入,表面毛刺与不平。

实性成分也有明显毛刺,叶间裂牵拉明显,表面有分叶征。

边缘紧贴叶间裂,密度较高。

病灶没有钙化,是软组织密度影。
临床考虑:
1、诊断问题:虽然有呼吸道的咳嗽症状,但病灶混合密度,收缩力明显,血管进入、边缘毛刺、胸膜牵拉、表面不平、密度不均,整体有收缩力与膨胀性,都是典型恶性的影像特征。所以极大概率就是恶性的,从密度与收缩力来讲,考虑浸润性癌可能性大,应该尽早手术。
2、手术方式:病灶仍有磨玻璃成分,位置靠边缘部位,如果术中病理没有报高危亚型(这种概率小),或含贴壁成分,由于小于2厘米,可以考虑亚肺叶切除加淋巴结采样。如果术中有报高危为主型,则可能切肺叶更为妥当点。
最后结果:
杭州市第一人民医院胸外科叶建明手术团队为其进行了手术,先楔形切除送术中快速切片,术中报贴壁为主的腺癌,局灶可疑浸润。那就没有有进一步切肺叶。但因实性成分占比高,考虑术后病理可能会升级或以腺泡或乳头亚型为主,所以淋巴结仍予以采样。

镜下见病灶表面胸膜皱缩,质较硬。

切下后见周围组织正常颜色,病灶处显灰白与表面皱缩。

剖面灰白,质较硬。

术中快速病理示腺癌,以贴生长为主,局灶可疑浸润。

常规病理示:浸润性腺癌,腺泡型70%,贴壁型20%,乳头型10%。淋巴结采了第4组、第7组、第8组、第9组、第10组均阴性,有神经侵犯,未侵犯胸膜。Ki67约3-5%阳性。
感悟:
今天分享的这个从影像上来看是很典型恶性的混合磨玻璃密度病灶,诊断并不难,主要特别之处在于是**科主任的亲戚,所以下定决心时与外人不太一样。此外病灶混合密度,术中病理贴壁为主,术后其实是有升级的,若真贴壁为主是高分化,现在是腺泡与乳头状亚型为主,是中分化腺癌。对于楔形切除是否足够要不要再升级行肺叶切除
















































